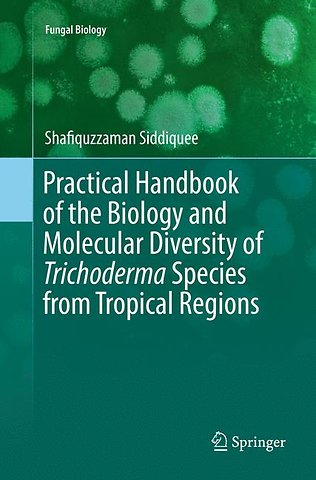

Practical Handbook of the Biology and Molecular Diversity of Trichoderma Species from Tropical Regions
Samenvatting
This book analyzes the right pathway to solve the controversial identifications of some Trichoderma species on the basis of sampling procedures, slide culture techniques, macroscopic and microscopic analysis, and molecular tools.
Most species of the genus Trichoderma grow rapidly in artificial culture and produce large numbers of small green or white conidia from conidiogenous cells located at the ends of conidiophores. The morphological characters are reported to be variable to a certain degree in their color, shape of conidia, conidiophore, pustules, and phialade. These characteristics allow a comparatively easy means of identification of Trichoderma as a genus but the species concept is difficult to deduce and there is considerable confusion over the application of specific names.
This work provides an essential link between data and taxa as a means to verify the taxonomic characters of the strains sequenced, and macroscopic and microscopic characteristics. Otherwise, a species level identification study cannot be corrected or uncorrected, and the user has to rely on the person perhaps making a mis-identification.